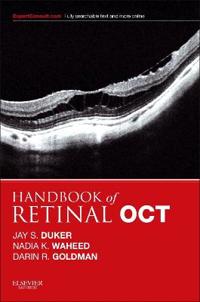
Handbook of Retinal OCT: Optical Coherence Tomography

Övrigt
Handbook of Retinal OCT: Optical Coherence Tomography
avJay S. Duker
Beskrivning:
With Handbook of Retinal OCT, you can master the latest imaging methods used to evaluate retinal disease, uveitis, and optic nerve disorders. Ideal at any stage of your career, this easy-to-use, clinically oriented handbook provides a quick, templated, and portable guide for the interpretation of Op [...]
Visa längre beskrivning
Fakta
- ISBN:
- 9780323188845
- Bandtyp:
- Övrigt
- Utgiven:
- 2014-01
- Språk:
- Engelska
- Antal Sidor:
- 190
Priser hos nätbutiker
| Butik | Mervärde | Pris | Tillgänglighet | Leveranstid | Inkl frakt | Länkar |
|---|---|---|---|---|---|---|
 |
Över 6 miljoner titlar Fraktfritt över 100kr Medmera-återbäring på alla köp | 812.00 kr | I lager | 5-8 dagar | 812.00 kr | Till butik |
 |
Nordens största bokhandel med över 10 miljoner titlar. Alltid låga priser | 1128.00 kr | I lager | 2-5 dagar | 1128.00 kr | Till butik |
Obs! Glöm inte att alltid kolla priset hos återförsäljaren!

